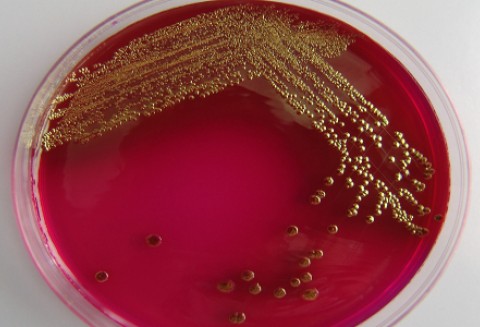
Białoruś – Wstrzymano dostawę unijnych warzyw do Rosji

Wiadomości
Logowanie
Mimo zatrzymanego tranzytu unijnych warzyw do Rosji Białorusini dalej mogą je importować do swojego kraju.
Zobacz inne aktualności z Kategorii:
Warzywa
Po tym jak Rosjanie w obawie przed epidemią wywołaną przez bakterię E.coli wprowadzili embargo na unijne warzywa tranzyt warzyw ze Wspólnoty został wstrzymany przez białoruskie władze.
Według tamtejszego ministerstwa zdrowia, zaistniała sytuacja nie ma nic wspólnego z zakazem rosyjskim, ale wynika z troski o obywateli oraz by nie dopuścić do rozszerzenia się choroby. Dlatego też warzywa te nie będą podawane w stołówkach placówek oświatowych oraz przedszkolach, a także sanatoriach i szkolnych obozach stacjonujących na Białorusi. Również zostanie wprowadzona wzmożony nadzór nad osobami przekraczającymi granicę.
źródło: Gospodarz.pl/Bankier.pl
Tagi powiązane z tym artykułem:
Tematycznie podobne wiadomości
-
Kategoria: Przetwórstwo spożywcze
Unia Europejska wprowadzi tylko 150 tys. ton cukru pozakwotowego
2013-01-30,czytaj więcej
-
Kategoria: Dotacje i dopłaty
2013-01-29,czytaj więcej
-
Kategoria: Z kraju
2013-01-30,czytaj więcej
-
Kategoria: Dotacje i dopłaty
Ambitne cele prezydencji Irlandii w zakresie reformy Wspólnej Polityki Rolnej
2013-01-30,czytaj więcej
-
Kategoria: Dotacje i dopłaty
2013-01-30,czytaj więcej
Komentarze do wiadomości
Nie ma żadnych komentarzy! Możesz być pierwszą osobą, która skomentuje tę wiadomość. Komentarze mogą zamieszczać tylko zarejestrowani użytkownicy.
Jeśli nie masz jeszcze konta zarejestruj się.
Publikowane komentarze są prywatnymi opiniami użytkowników portalu. Gospodarz.pl nie ponosi odpowiedzialności za treść opinii. Dodając komentarz akceptujesz regulamin serwisu.
Ze świata
Rola, kształt i znaczenie Wspólnej Polityki Rolnej [video]
W coraz większym stopniu przedłużają się negocjacje w sprawie rozdysponowania finansów unijnych na kolejne 6 lat. W oczekiwaniu na rezultaty prowadzonych konsultacji zapraszam do obejrzenia krótkiego materiału video traktującego o znaczeniu WPR dla rolnictwa oraz jej kształcie na najbliższe lata. czytaj więcej
Z kraju
Biznes
Finanse
Ambitne cele prezydencji Irlandii w zakresie reformy Wspólnej Polityki Rolnej
Od 2013 roku w Polsce zwiększył się zakres kontroli tzw. wymogów wzajemnej zgodności w gospodarstwach rolnych (cross compliance - obszar C)
W 2012 roku rynek w branży leasingowej zwolnił. Wyraźny wzrost leasingu maszyn rolniczych i maszyn dla przemysłu spożywczego
ELF - aplikacja do wypełniania i drukowania wniosku o dopłaty do materiału siewnego [pobieralnia]

Dodaj do schowka
Śledziku
Facebooku
